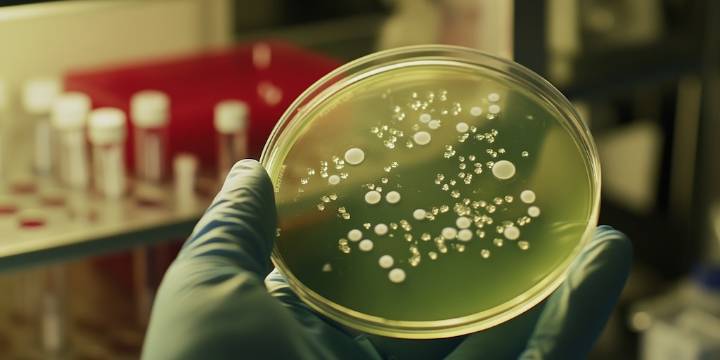
Un nuevo tratamiento con fototerapia podría lograr que bacterias resistentes respondan otra vez a los antibióticos

Un descubrimiento innovador en Reino Unido reaviva la esperanza en la lucha global contra las bacterias resistentes. Investigadores del Francis Crick Institute en Londres presentaron un método que utiliza compuestos activados por luz para debilitar la defensa de bacterias como Escherichia coli (E. coli) y devolverles la susceptibilidad a los medicamentos tradicionales.
El hallazgo , publicado en el Journal of the American Chemical Society , plantea un camino novedoso para enfrentar un problema que preocupa a autoridades sanitarias de todo el mundo.
¿Por qué la resistencia a los antibióticos es una amenaza?
La resistencia a los antibióticos ocurre cuando las bacterias dejan de responder a los medicamentos diseñados para eliminarlas o frenar su crecimiento. Esta situació

Infobae
El Destape Sociedad
Raw Story
News 5 Cleveland
The Cut
Political Wire